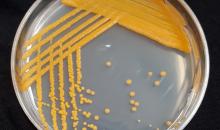

Rhodococcus fascians(CORBFA)
Overview Code created in: 2002-02-13
- EPPO Code: CORBFA
- Preferred name: Rhodococcus fascians
- Authority: Tilford
The current host range of R. fascians encompasses over 87 genera belonging to 40 plant families
| Name | Authority |
|---|---|
| Corynebacterium fascians | (Tilford) Dowson |
| Name | Language |
|---|---|
| cauliflower disease of ornamentals | English |
| cauliflower disease of strawberry | English |
| fasciation of strawberry | English |
| leafy gall of ornamentals | English |
| leafy gall of tobacco | English |
| pistachio bushy top syndrome | English |
| Bakterienkrebs: Zierspargel | German |
| Blattgallen: Begonie | German |
| Verbänderung: Erdbeere | German |
| Verbänderung: Zierpflanzen | German |
| chou-fleur du fraisier | French |
| fasciation des plantes ornementales | French |
| frisée du fraisier | French |
| gale foliaire des plantes ornementales | French |
| arrepollado de las hojas de la fresa | Spanish |
| fasciación de la fresa | Spanish |
Kingdom
Bacteria (
1BACTK )
Family
Nocardiaceae (
1NOCRF )
Genus
Rhodococcus (
1RHDCG )
Species
Rhodococcus fascians (
CORBFA )